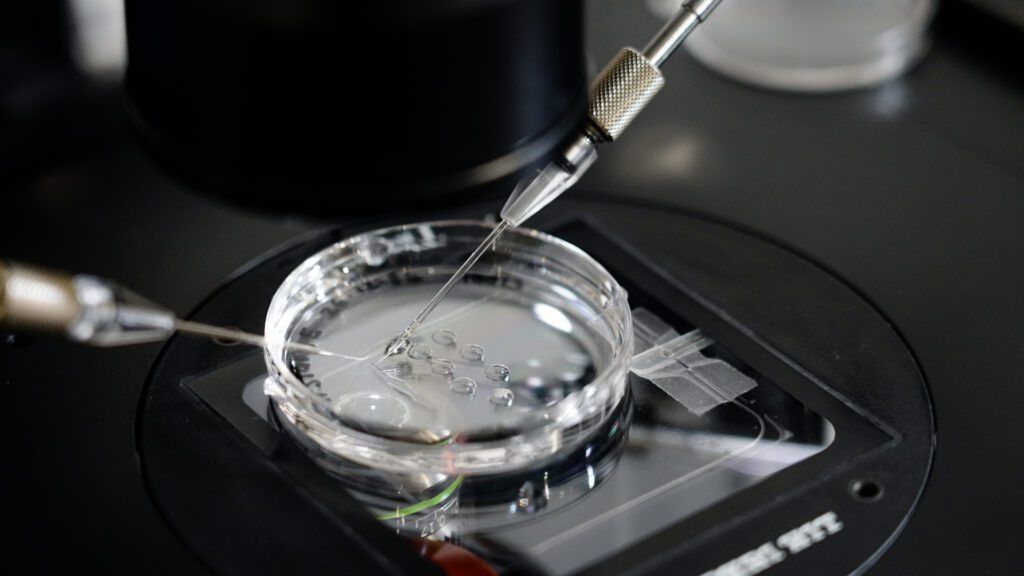
IVF egg and sperm collection

What is In Vitro Fertilisation - And How Does it Work?
In Vitro Fertilisation - known as IVF - was once a medical miracle. We’ve come a long way since 1978 when the world’s first IVF baby was born with IVF now considered a mainstream medical treatment.

In Vitro Fertilisation - known as IVF - was once a medical miracle. We’ve come a long way since 1978 when the world’s first IVF baby was born with IVF now considered a mainstream medical treatment. Thanks to Australian IVF clinics, over 17,900 IVF babies1 are welcomed annually. But what is IVF, and how does it work?
In this blog, we go beyond the basics of IVF to explore the process itself including what happens in the laboratory. This will give you a greater understanding of what to expect during an IVF cycle but please note that the information in this blog is a general guide only, your IVF cycle with Adora Fertility is unique and tailored to you.
What is In Vitro Fertilisation (IVF)?
In Vitro Fertilisation is one of the most common treatments for infertility, where eggs are fertilised with sperm ‘in vitro’ – which means the process happens in a laboratory ‘in glass’ instead of inside the human body. Because In Vitro Fertilisation ensures that eggs and sperm are brought together, it overcomes many fertility issues such as fallopian tube issues, sperm motility issues, age related infertility and unexplained infertility.
How Does In Vitro Fertilisation Work?
Although the term ‘In Vitro Fertilisation’ sounds complex, the way IVF works is actually quite simple.
Eggs and sperm are combined in an IVF clinic laboratory in the hope that the eggs fertilise and develop into healthy embryos for transfer into your uterus for pregnancy. Whether this happens successfully depends on several factors, including your age at the time of egg collection - which determines the quality of your eggs – and the quality of the sperm used in your IVF treatment.
The IVF Process: What to Expect During IVF
The IVF process is not as long as you may think, one full cycle can be completed in 4-6 weeks. To help you understand what to expect during IVF, here’s a quick six-step overview of a typical IVF cycle at Adora Fertility.

Remember that your IVF cycle may involve varying processes, timings and medications, depending on your infertility diagnosis and circumstances, but you will follow these six steps.
Step 1: Ovarian Stimulation
The first step in the IVF process is ovarian stimulation, which involves taking medications to increase the number of mature eggs which, in turn, increases the chances of pregnancy.
This usually involves self-injecting controlled doses of fertility hormones for around 10-12 days. These injectable hormones are the same ones your body naturally produces for egg growth so mimics the body’s natural ovulatory cycle.
Step 2: Monitoring

Once ovarian stimulation is underway, you will be carefully monitored to check your ovarian response and see how your eggs are developing. This is a critical part of the IVF process to ensure you are safely responding to the fertility hormone injections and producing a good number of eggs for your treatment.
When your eggs are at the right growth stage, you will be booked in for egg collection.
Step 3: Egg & Sperm Collection
Step three of the IVF process involves collecting your eggs and preparing the sperm that we will be using in your IVF cycle. Egg collection is not a painful procedure and, at Adora, is performed under anaesthetic (heavy sedation) and usually takes 15 – 30 minutes. The follicles within the ovary are aspirated with a fine needle and the follicular fluid examined under a microscope to check for the number of eggs. After your procedure we will be able to tell you how many eggs have been collected.
On the same day, a sperm sample is collected from your partner, or donor sperm prepared if you are using a sperm donor. The sperm is carefully analysed by our embryologists and then washed – a process which ensures only the best, most motile sperm remain in the sample, ready to fertilise your eggs. You can learn more about this important process in our blog on sperm preparation for fertility treatment here.
Step 4: Fertilisation
Once the egg and sperm are collected and prepared, they are brought together using either IVF or ICSI. Your fertility specialist will decide which is most suitable for you. With IVF, the eggs and sperm are placed in a petri dish and the egg and sperm come together naturally in the same manner that would occur in natural conception. This process is called insemination.
The inseminated eggs are placed in specialised IVF incubators overnight and the next day examined under a microscope to check for signs of fertilisation. If fertilisation has occurred and the fertilised egg continues to grow and develop, an embryo forms. You will be notified of the number of eggs which have successfully fertilised. Once fertilised they are cultured in the incubator and left undisturbed (as this is how they best develop) until the day of embryo transfer. For the majority of patients it is preferable to grow the embryo for 5 days, to the blastocyst stage, before embryo transfer.
Step 5: Embryo Transfer
Embryos are graded based on cell number and quality and the best embryo is selected for transfer. If you have multiple good embryos, they can be frozen for future use in a Frozen Embryo Transfer (FET). Embryo transfer day can be an exciting but daunting time. The embryo transfer procedure is similar to having a pap smear, most women can return to their normal activities on the same day.
After the transfer, you will be given instructions including any medications you need to support your body and to help the embryo implant. Now all you need to do is wait, which we understand can be one of the most difficult times.
Step 6: Pregnancy Test
Around 11 days after your embryo transfer, we perform a pregnancy blood test to see if your hCG (human chorionic gonadotropin) level shows that you are pregnant. HCG is a hormone produced once the embryo has successfully implanted and rises as your pregnancy progresses.
Although tempting, it’s important not to test early using an over-the-counter urine pregnancy test, as you may get an inaccurate result. If your blood test shows hCG at the expected levels, congratulations, you’re pregnant!
There are many reasons why an IVF cycle may or may not result in a pregnancy. Each IVF cycle gives your fertility specialist the opportunity to learn about your response and, if unsuccessful, together you may plan to start a new cycle armed with these learnings.
Sources:
Assisted Reproductive Technology in Australia and New Zealand 2022 https://www.unsw.edu.au/content/dam/pdfs/research/2024-09-npesu/2024-09-assisted-reproductive-technology-in-australia-and-new-zealand-2022.pdf
Related Articles

The Two Week Wait
If you are trying to conceive you will be familiar with the ‘two week wait.’ This is the stretch o...

How to increase chances of pregnancy
Planning to try for a baby? Beginning your journey or expanding your family is an exciting time. A...

Egg Freezing Facts
Ten egg freezing myths busted. Are you considering freezing your eggs? With so much information on...